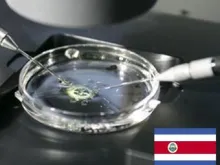

Últimas noticias
CIDH abriria as portas ao aborto na América Latina, alerta pró-vida espanhola
Mercedes Martínez Albesa, líder pró-vida espanhola, advertiu que nesta sexta-feira, 5 de outubro, dia em que a Corte Interamericana de... Leia mais
Pedem que a Costa Rica evite a imposição do aborto na América Latina
Sessenta e seis organizações pró-vida da América Latina lidaram para Costa Rica para não permitir que a Corte Inter Americana... Leia mais
Costa Rica: Congresso Internacional reflete sobre o respeito à vida
Entre os dias 28 e 30 de outubro se realizará na Universidade Latina de San José (Costa Rica) o 5º... Leia mais
Enviado papal à Costa Rica: Fecundação in vitro profana a vida do não nascido
Durante a Missa de encerramento do ano jubilar pelo 375º do encontro da imagem de Nossa Senhora dos Anjos, Padroeira... Leia mais
Bento XVI alenta devoção a Nossa Senhora dos Anjos, Padroeira da Costa Rica
Em uma carta enviada aos católicos da Costa Rica pelo encerramento do Ano Jubilar em homenagem a Nossa Senhora dos... Leia mais
Pró-vidas convocam à manifestação contra a fertilização in vitro na Costa Rica
Organizações civis que defendem a vida convocaram na Costa Rica a uma manifestação que será realizada na terça-feira 26 de... Leia mais
Costa Rica receberá relíquias do Beato João Paulo II
Com uma Missa celebrada no Santuário e Paróquia Nuestra Señora de la Limpia Concepción del Rescate (Costa Rica), Dom José... Leia mais
Após censura da campanha católica contra fecundação in vitro, responsáveis apelam da sentença do Governo
O governo da Costa Rica ordenou que a Rádio católica Fides suspendesse uma campanha publicitária chamada "A fecundação in vitro... Leia mais
Costa Rica será sede do V congresso internacional pró-vida
"A transmissão da vida: uma maravilha da criação", é o título do V Congresso Internacional Pró-vida que se realizará entre... Leia mais
Costa Rica rechaça lei da fecundação in vitro
Depois de uma apertada votação de 26 votos a favor e 25 contra na câmara de deputados, os legisladores da... Leia mais
Anunciam congresso internacional pró-vida na Costa Rica
Ante o debate atual na Costa Rica de um projeto que busca aprovar a fertilização in vitro, a Associação Por... Leia mais